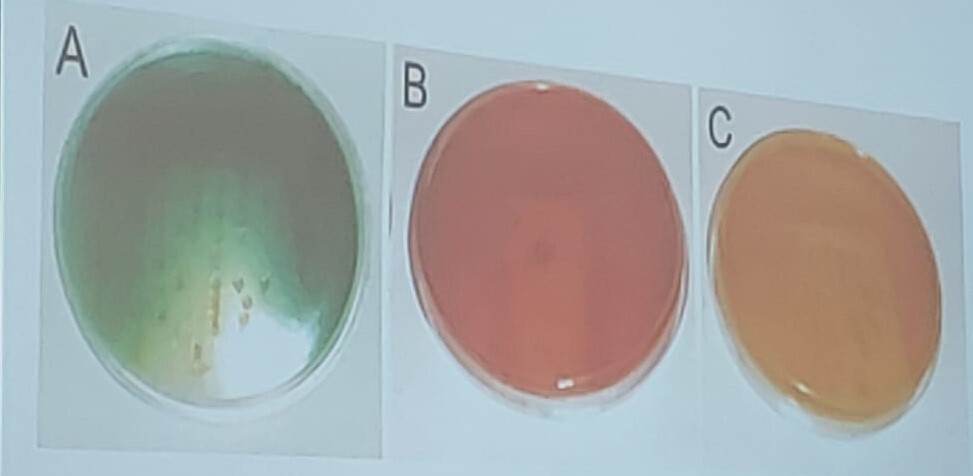

Caraceterísticas microbiológicas
- Bacilos gramm- largos (muchas veces en parejas pero en paralelo NO forman cadenas).
- Aerobios
- Pigmentos mucoides (en el cultivo)
-Pioverdina
-Piocianina
-Piorrubina - Pocos requerimientos nutricios
Factores de virulencia
Agrupados en 4 grupos
- Adhesinas (más importante)
-Flagelos
-Pilis
-LPS (inmunogénicos)
-Alginato (exopolisacárido mucoide formador de biofilm), no todas las cepas producen la misma cantidad, hiper tienen mutación en el gen mucA. - Exotoxinas
-Exotoxina A: inhibe síntesis de proteínas
-Hemolisinas y enzimas degradadoras de tejidos (elastasas, proteasas, fosfolipasas). - Piopigmentos (mediadores de la respuesta inmunogénica)
-Piocianina: estimula IL-8 y producción de superóxido y H2O2
-Pioverdina: sideróforo - Múltiples mecanismo de resistencia a antibióticos
-Mutación de porinas: impiden entrada del antibiótico a la bacteria
-Resistencia INTRINSECAS (por su propio característica biológica, no porque muto).
NOTAS
Alginato
Alginato (exopolisacárido mucoide formador de biofilm), no todas las cepas producen la misma cantidad, hiper tienen mutación en el gen mucA.
Px que se infecto por una cepa de pseudomonas, con la mutación en mucA tiene infecciones más difíciles de erradicar.

INFECCIONES CUTÁNEAS
-px NO estaban en hospitales
Pseudomonas
No se asocian tanto a la permanencia de hospitales
- Ectima gangrenoso
- Hot-tub folliculitis
ECTIMA GAGRENOSO
Explicala, bacteria, px, etc.
El fondo se vuelve necrótico (se corrige cirugía).
- En px que tienen →
Infecciones en quemaduras profundas (2 y 3).
PISTA: la secreción se pone amarrilenta, verdosa fosforecente/brillante por los pigmentos.
- Otro mecanismo de adquisición de estas bacterias→
Heridas en suelas (osteocondritis) (las pseudomonas les gusta los ambientes humedos y contaminan los tenis. Px que se hacen una herida con un clavo y atraviesa la suela, se pueden infectar), aparte de ectima gangrenoso también puede producir osteocondritis si el clavo penetro muy profundo puede que toque el hueso o articulación y las pseudomonas lo producen.

Hot-tub folliculitis
Explicala, bacteria, px, etc.
- Factor de riesgo: uso de jacuzzi / tinas calientes.
- Se inflaman los foliculos y se foman microabscesos dentro de ellos.

INFECCIONES
-px NO estaban en hospitales
Pseudomonas
- Otitis externa (oído de nadador)
- Queratitis bacterianas asociadas a lentes de contacto
Otitis externa-oído de nadador
Explicala, bacteria, px, etc.
- Factor de riesgo: acumulo de agua en el canal auditivo externo.
- Muy dolorosa (px que luego llegan de la playa a urgencias porque llevan manteniendo humedad en el oído y terminan por desarrollar infecciones por pseudomonas).
- Muy inflamado
- Lleno de pus canal auditivo

Queratitis bacterianas asociadas a lentes de contacto
Explicala, bacteria, px, etc.
- Inflamación de la córnea
- Los lentes de contacto se guardan en medios acuosos (pseudomonas aman el agua) y se terminan contaminando de pseudomonas por no una buena ingiene de ellos.

INFECCIONES
-px SI estaban en hospitales
Pseudomonas
- Infecciones pulmonares:
-Empiezan con una colonización asintomática a → traqueobronquitis o neumonía necrosante. - Infecciones nosocomiales
INFECCIONES PULMONARES
-px SI estaban en hospitales
Explicala, bacteria, px, etc.
-Empiezan con una colonización asintomática a → traqueobronquitis o neumonía necrosante.
Factor de riesgo:
* Px con traqueostomía
* Px con ventilación mecánica
* Px con fibrosis quística (tienen alterada la secreción de cloro y esto produce una secreción de mucho moco).
(estos px se van colonizando porque tenian un tubo endrotraqueal que permitió la entrada de las pseudomonas al interior de los pulmones. Secretando moco y pus).

INFECCIONES NOSOCOMIALES
-px SI estaban en hospitales
Explicala, bacteria, px, etc.
Infecciones asociadas a la atención de salud
* Neumonía asociada a ventilador
* IVU asociada a sonda urinaria
* Bacteriemia asociada a catéter
Tx
Pseudomonas
- Uso previo de antibióticos es un factor de riesgo (presión selectiva)
- Si se sospecha, utilizar medicamentos antipseudomónicos
- ALTO RIESGO DE RESISTENCIAS


